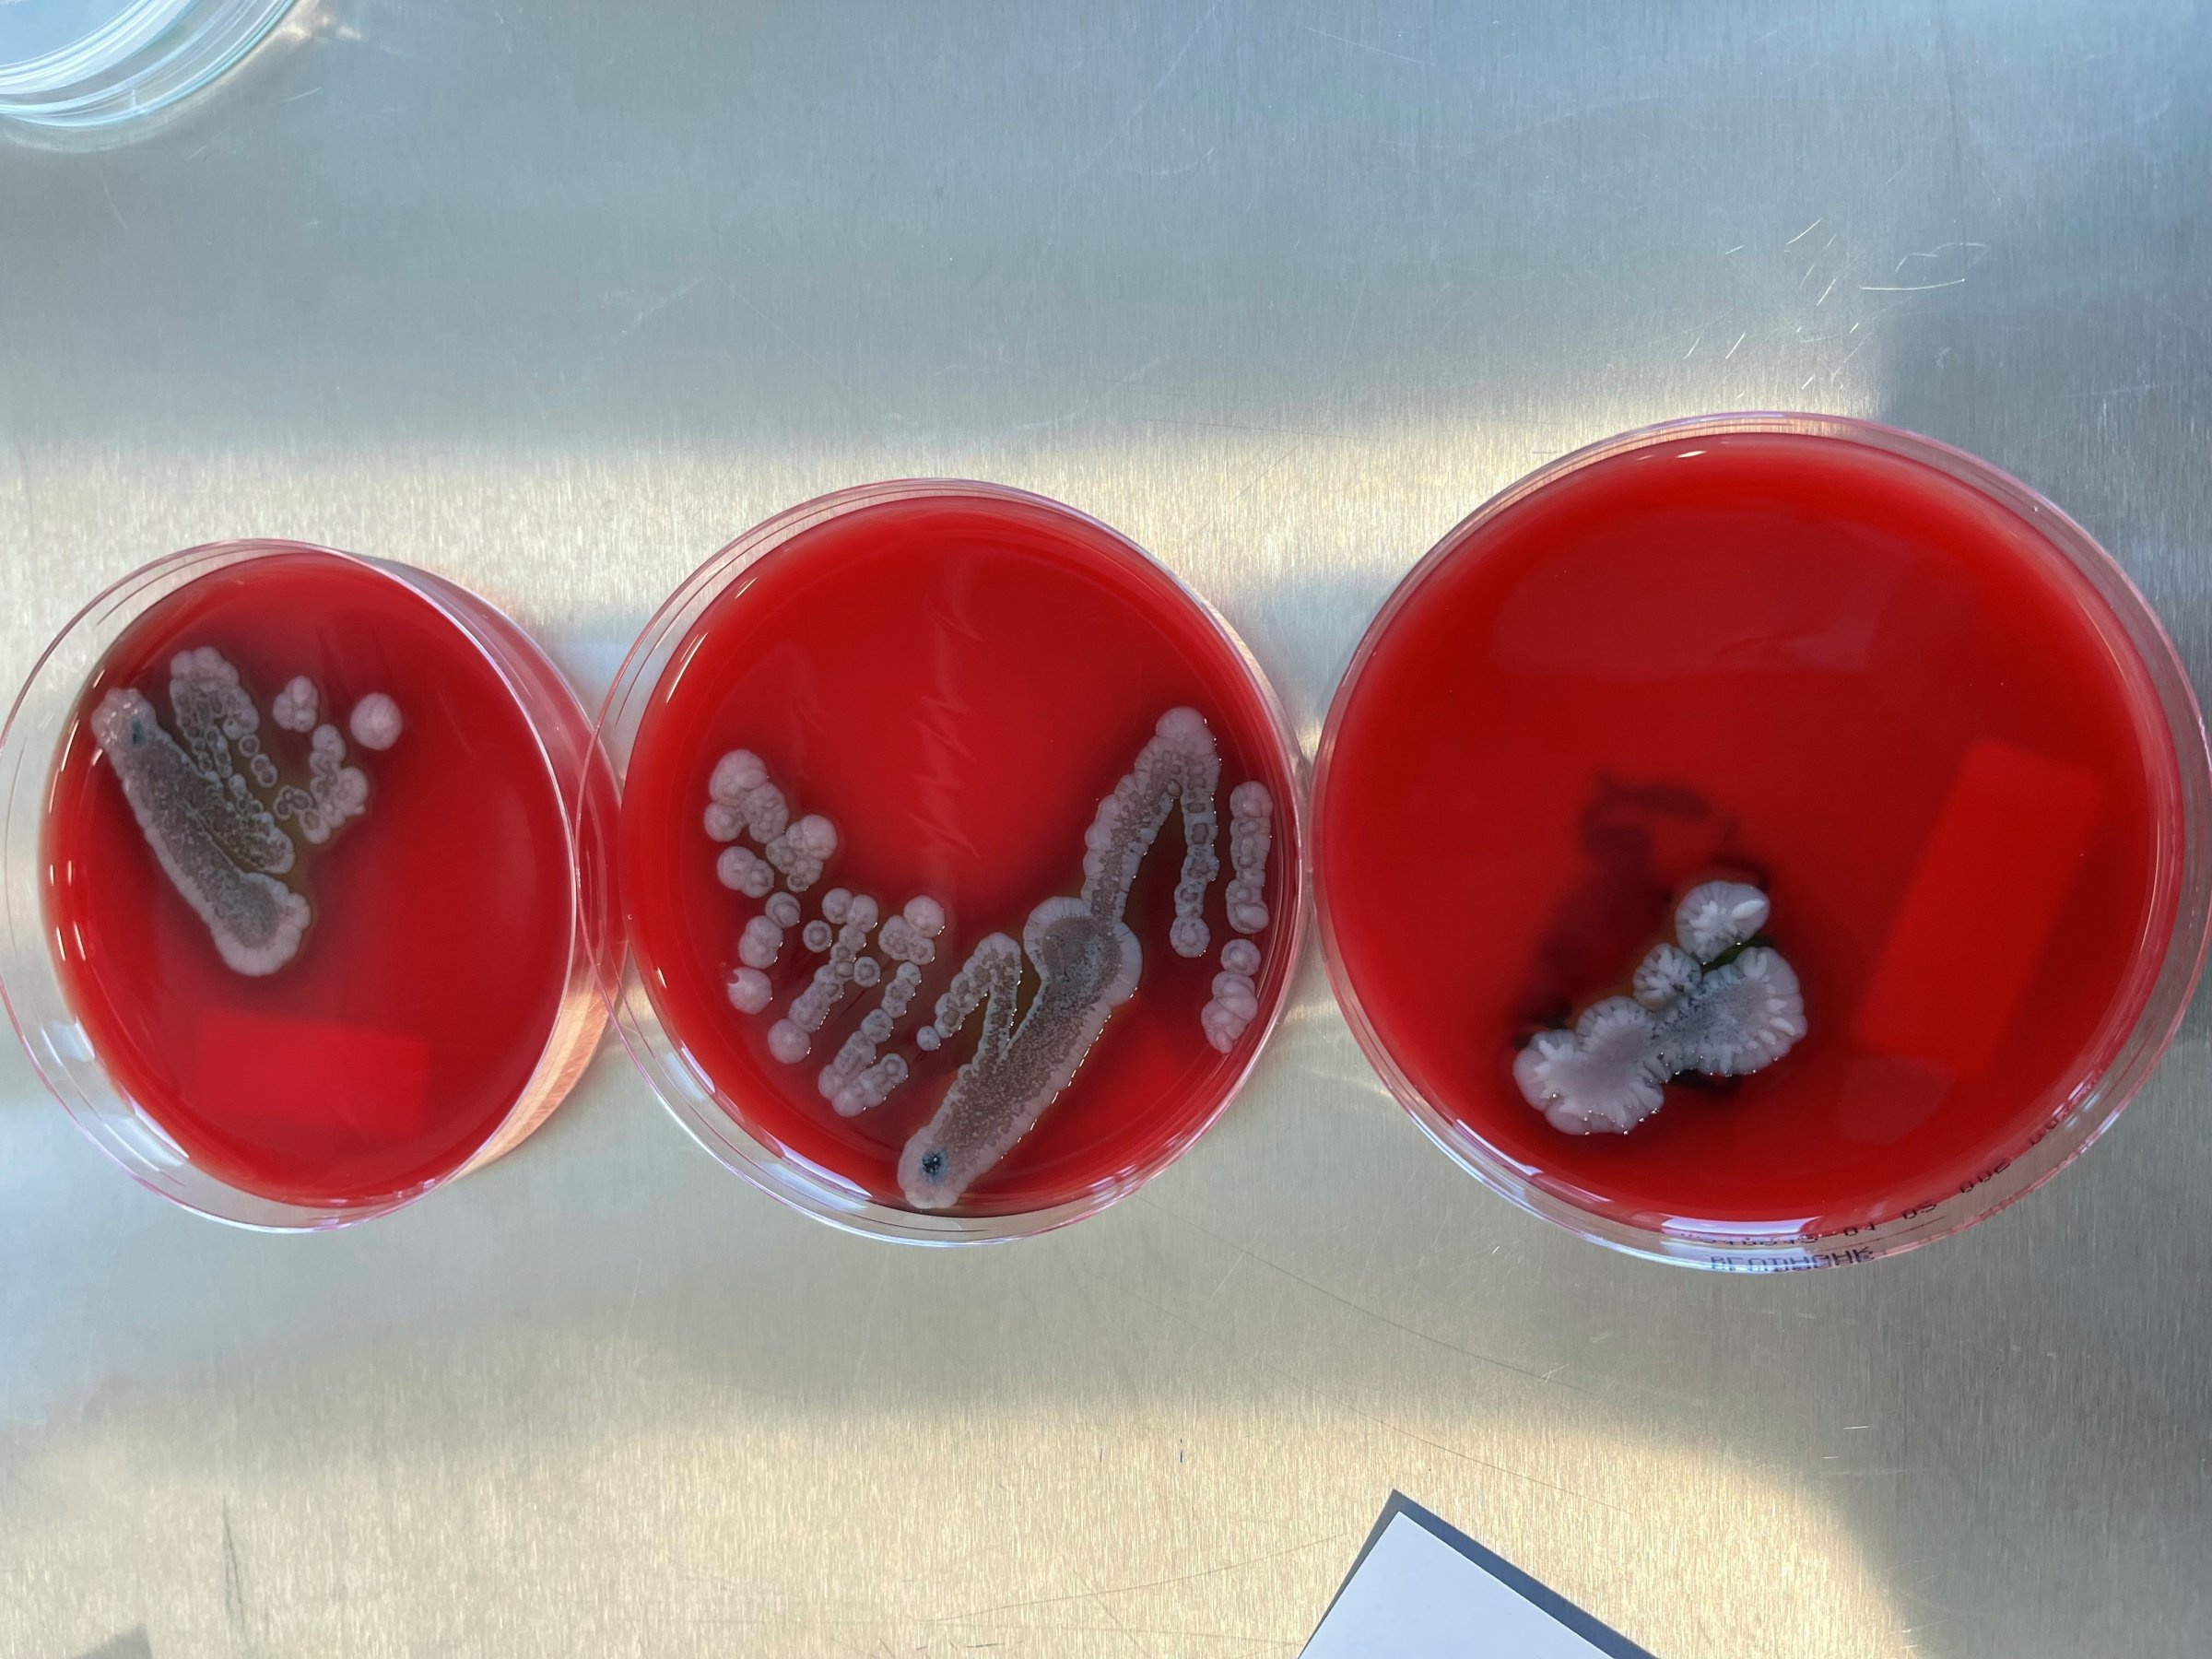

Fant smitte hos pukkellaks
Veterinærinstituttets helseovervåking av pukkellaks påviste ikke alvorlige meldepliktige fiskesykdommer. Viruset PRV-1 som gir hjerte- og skjelettmuskelbetennelse hos atlantisk laks ble funnet i pukkellaks fra tre elver. Det ble også funnet pukkellaks med en bakteriesykdom som vanligvis forekommer i varmere strøk og som kan gi infeksjon også hos mennesker. Overvåkingen har dermed bidratt med ny kunnskap om pukkellaksens betydning i Norge.

Antall invaderende pukkellaks i norske elver har tidoblet seg i 2021 sammenlignet med 2019, melder Statsforvalteren i Troms og Finnmark. Pukkellaksen er en fremmed art i Norge, men har etablert selvreproduserende bestander i norske elver etter utsettinger i Russland. Fjorder og elver i østlige deler av Troms og Finnmark er hardest rammet, men arten ble registrert i elver langs hele kysten, inklusiv vår sør-østligste elv Enningdalselva.
–Omfanget av pukkellaksinvasjonen i 2021 overrasket både forskere og forvaltning, sier Åse Helen Garseth - fagansvarlig for villfiskhelse i Veterinærinstituttet. Det er et stort behov for kunnskap om de økologiske og økonomiske effektene av pukkellaksinvasjonene, og om de kan bidra til introduksjon eller spredning av smittestoff.
Veterinærinstituttets undersøker smittestatus hos pukkellaks både gjennom overvåkingsprogram og gjennom meldinger fra publikum til syk villfisk-portalen.
Påviste virus
Gjennom prosjektet Havets helse organiserte Veterinærinstituttet prøveuttak fra pukkellaks fra elvene Karpelv og Skallelv på henholdsvis sørsida og nordsida av Varangerfjorden, samt Skibotn og Signaldalselva ved Lyngenfjorden. I tillegg har vi mottatt, og mottar fortsatt, frossen pukkellaks fra andre elver og fra sjø langs kysten. Her har vi samarbeidet tett med Norsk institutt for naturforskning (NINA), Masterstudent Tora Paulsen ved Universitetet i Tromsø, lokale elveeierlag og kultiveringsanlegg, forteller Åse Helen Garseth.
Veterinærinstituttet har undersøkt totalt 181 pukkellaks. Materialet har inngått i Mattilsynets overvåkingsprogram for to virussykdommer hos laks - viral hemorrhagisk septikemi (VHS) og infeksiøs hemorrhagisk nekrose (IHN). I tillegg har vi undersøkt for infeksiøs lakseanemi virus (ILAV), Renibacterium salmoninarum (som gir bakteriell nyresyke) og piscine orthoreovirus-1 (PRV-1). Det ble ikke påvist smittestoff forbundet med meldepliktige sykdommer (VHSV, IHNV, ILAV eller R. salmoninarum). Derimot ble det igjen påvist PRV-1 hos åtte individer, henholdsvis fem i Skibotnelva, en i Skallelv og to fra Fersethvassdraget i Vega. PRV-1 smitte hos pukkellaks ble første gang påvist i Norge gjennom helseovervåkingsprogrammet for vill laksefisk i 2019. Sekvensering og slektsskapsstudier viste den gang at virus fra pukkellaks tilhørte PRV-1b som er den varianten som gir hjerte- og skjelettmuskelbetennelse (HSMB) hos atlantisk laks i oppdrett.
Kommer i stimer
Utfordringen med pukkellaksen er at den kommer inn i fjorder i store stimer - ofte kalt «flak». Før de går opp i elvene for å gyte forflytter stimene seg i fjordene og kan da fungere som en bro mellom populasjoner med ulik smittestatus, være seg oppdrettede eller ville laksefisk.
Vi vet ikke hvordan pukkellaksen forholder seg til oppdrettsanlegg, om de holder seg unna, ignorerer eller trekkes mot dem. Pukkellaks i elvene opptrer aggressivt mot annen fisk, og erfaringer fra Finnmark tyder på at vår egen atlantisk laks søker seg bort fra pukkellaks i elvene.
–Det er liten tvil om at pukkellaks i fjorder og elver kan endre smittedynamikken i systemene og at det å kjenne smittestatus da er viktig av flere årsaker, sier Garseth.
Fant varmekjær og potensielt zoonotisk bakteriesykdom hos pukkellaks
Sykdommer som kan overføres fra ville eller tamme dyr til mennesker eller fra mennesker til dyr, kalles zoonoser. I midten av august ble det en pukkellaks med furunkulose-lignende sykdomstegn funnet død i Gjersjøelva i Nordre Follo kommune. Follo jeger- og fiskeforening varslet Mattilsynet, som leverte pukkellaksen frossen til undersøkelse hos Veterinærinstituttet.
Ved dyrking på medier vokste bakterien Aeromonas hydrophila både fra muskler og nyre. Mistanken om furunkulose, som forårsakes av bakterien Aeromonas salmonicida subsp. salmonicida, ble dermed avkreftet, men funnet er likevel interessant. A. hydrophila finnes naturlig i vann, men kan under visse betingelser gi sykdom både hos fisk og folk. Hos fisk gir bakterien sykdommen hemorrhagisk septikemi, mens den hos mennesker kan gi sårinfeksjoner, men også mage-tarminfeksjoner. Infeksjoner med A. hydrophila forekommer fortrinnsvis i varmere strøk.
Funnet av A. hydrophila på pukkellaks har ført til at vi nå dyrker fra all frossen pukkellaks som leveres til Veterinærinstituttet. Undersøkelsene pågår fortsatt og viser så langt få funn av bakterier hos tilsynelatende frisk pukkellaks. Vi har ingen påvisninger av Aeromonas salmonicida subsp. salmonicida som gir furunkulose, men har én påvisning (sparsom vekst) av Pseudomonas fluorescens. Dette er også en bakterie som i blant knyttes til sykdom både hos fisk og mennesker.
Funnet av opportunistiske og potensielt zoonotiske bakterier hos pukkellaks er ikke dramatisk, men bør følges opp videre.
Påvirker vannkvalitet
Pukkellaks som kommer inn til elvene kan ha med seg bakterier og virus, men er også svekket og er mer mottakelig slik at den kan utvikling av sykdom forårsaket av mikroorganismer som finnes naturlig på fiskens egen hud og i miljøet rundt den.
Når slike bakterier får mulighet til å vokse og oppformeres i svekket og døende pukkellaks kan dette påvirke smittepresset til stedegen villfisk. I elver der store mengder død pukkellaks dør og nedbrytes vil vannkvaliteten utvilsomt påvirkes både i form av bakterievekst og frigjøring av næringsstoff. Dette kan påvirke balansen mellom mikrober i vannet og helsen til villfisk i elvene. Slike endringer bør også følges tett også fordi det kan forringe elvenes verdi som kilde til drikkevann, næringsliv og rekreasjon.
Veien videre
Hos vår nabo i øst opprettholdes pukkellaksbestandene fordi arten forvaltes som en ressurs. Samtidig viser modelleringer at de pågående klimaendringene kan øke forekomsten av pukkellaks. Det levnes derfor liten tvil om vi må leve med denne fremmede arten i årene fremover. Det er enighet i forskningsmiljøene om at vi i dag kun overvåker de økologiske effektene av pukkellaks mens det i liten grad foregår reell forskningsaktivitet på temaet. Med fortsatt store endringer i havtemperatur, isdekke og isgang i elvene er det behov for mer kunnskap om hvordan situasjonen vil utvikle seg over tid. Vi må vite mer om hvor pukkellaksen vil forekomme i fremtiden, hvordan den påvirker økosystemer, hvilke konsekvenser den har for vannkvalitet og for smittebelastning for både mennesker, vill og oppdrettet fisk. Behovet for kunnskap om hvordan vi kan leve med arten ved å redusere negative effekter og samtidig gjennomføre målrettet bekjempelse er stort.